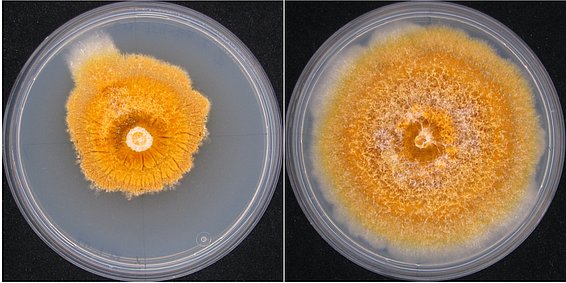

Studying the genetic diversity of fungi forms the backbone of my scientific career. For several years, I have also expanded my understanding of fungal biology to include the interaction between fungi and associated viruses.
A major achievement of my early work is the transition from a morphology-based to a genetic variability-based understanding of biodiversity at the species and population level. To study lichen fungi and other understudied organisms, I developed new molecular techniques, described new lichen species, reconstructed their evolutionary history, and deciphered the genetic diversity of threatened species.
After my PhD, I focused on studying the biology of invasive fungal pathogens (e.g., Cryphonectria parasitica, Fusarium circinatum), developed new methods for population studies, and also described new tree parasitic species (Cryphonectria carpinicola).
To study the virome of tree pathogens relevant to Switzerland, I have established a collaboration with the virology lab of Prof. Nobuhiro Suzuki at Okayama University (Japan), where I could work in 2020 and 2022 to deepen my biological and technical knowledge of viruses. In addition, I integrated new technical approaches to RNA sequencing in my studies: Nanopore Technologies, PacBio, and Illumina RNA-seq.